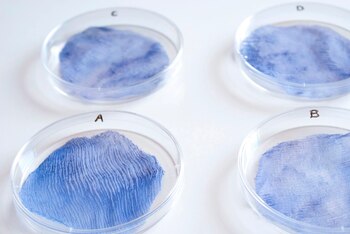
Muestras de tejidos cultivados a

En los últimos años, laboratorios de biomoda y diseñadores experimentales han impulsado una transformación radical en la industria textil, al desarrollar materiales biodegradables cultivados a partir de organismos vivos como hongos, algas, flores y bacterias. Esta tendencia, que fusiona biología, arte y diseño, propone una alternativa regenerativa frente a la moda industrial tradicional, responsable de más del 10 % de las emisiones globales y de millones de toneladas de residuos textiles cada año.
En ciudades como Nueva York, instituciones como el Biogarmentry Lab de la Parsons School of Design y el Fashion Institute of Technology se han convertido en epicentros de experimentación con materiales vivos. Allí, diseñadoras como Charlotte McCurdy han creado prendas a base de algas, mientras empresas como Bolt Threads desarrollan biotextiles de micelio, el tejido subterráneo de los hongos.
En Europa, iniciativas como Biomimicry Lab en Londres, Grow Your Own Couture en los Países Bajos y Studio Rosella Nicolini en Italia exploran nuevas posibilidades para la moda sostenible. En América Latina, figuras como Carolina Arévalo en Chile y el colectivo Biotecnología Textil MX en México producen fibras de kombucha y biocuero vegetal, ampliando el alcance de estos desarrollos.
El proceso de creación de estos textiles vivos varía según el organismo utilizado. El micelio se cultiva en moldes para formar estructuras resistentes y ligeras, comparables al cuero animal. Las algas se transforman en bioplásticos y fibras completamente biodegradables. Por su parte, flores y hojas se emplean en técnicas de impresión natural o en tejidos que incorporan pigmentos vivos, mientras que ciertas bacterias generan celulosa o colorantes orgánicos libres de tóxicos. El resultado son materiales que pueden crecer, repararse y, al final de su vida útil, degradarse sin dejar residuos contaminantes, cerrando así el ciclo de vida del producto.
El impacto de esta innovación va más allá de lo técnico. Según reportajes de The New York Times, Vogue Business y Wired, la biomoda redefine la relación entre el ser humano, la naturaleza y la ropa, proponiendo prendas que literalmente florecen, respiran o se transforman.
Esta dimensión estética y filosófica se refleja en las palabras de la diseñadora Scarlett Yang, quien afirmó: “Mis prendas exhiben la belleza de las formas de vida naturales, con el objetivo de desafiar la percepción del público sobre los ciclos de vida de los materiales”, según declaraciones recogidas por Dezeen.

No obstante, la adopción masiva de estos biomateriales enfrenta desafíos significativos. La escalabilidad de la producción sigue siendo limitada y los costos, elevados. Además, la durabilidad de algunos tejidos depende de condiciones ambientales específicas, lo que plantea interrogantes sobre su conservación. La percepción del consumidor constituye otro obstáculo, ya que requiere una labor educativa para valorar el aporte ecológico de estas prendas. Por último, la regulación y certificación de los nuevos materiales biológicos es un campo en desarrollo, según análisis de Fast Company y El País Retina.
El atractivo sensorial de estos materiales ha sido destacado por líderes de la industria. Matt Scullin, director ejecutivo de MycoWorks, sostuvo en una entrevista con The Guardian: “Puede provocar la misma respuesta emocional que el cuero animal. Tiene esa sensación de rareza al tacto”. Por su parte, Dan Widmaier, CEO de Bolt Threads, remarcó durante una conferencia TED, según Quartz: “Nadie ama el cuero porque provenga de una vaca”.

La convergencia de ciencia, arte y sostenibilidad en la biomoda no solo apunta a eliminar los residuos textiles, sino que también invita a repensar el acto de vestirse como un gesto de reconexión simbólica con la naturaleza.
Últimas Noticias
El precio de los condominios en Miami cayó casi 10% mientras el mercado inmobiliario registra una alza en viviendas asequibles
Las ventas de viviendas económicas aumentan por la baja de tasas y la entrada de compradores extranjeros, mientras el segmento de lujo alcanza cifras récord

Estados Unidos postergó hasta el 2027 los nuevos aranceles a semiconductores chinos
Algunas empresas estadounidenses solicitaron certidumbre sobre el calendario de futuras regulaciones
El precio del petróleo subió por expectativas de un mayor crecimiento económico en Estados Unidos
El mercado evalúa si la demanda sostendrá los precios o si será necesaria una intervención del banco central para evitar presiones inflacionarias
Un hombre fue sentenciado por planear un ataque al estilo del 11 de septiembre en el Bank of America Plaza de Atlanta
El ciudadano keniano Cholo Abdi Abdullah, fue condenado a dos cadenas perpetuas consecutivas tras planear secuestrar un avión comercial y estrellarlo en el recinto. Su compromiso con el ataque terrorista lo llevó a formarse como piloto comercial



